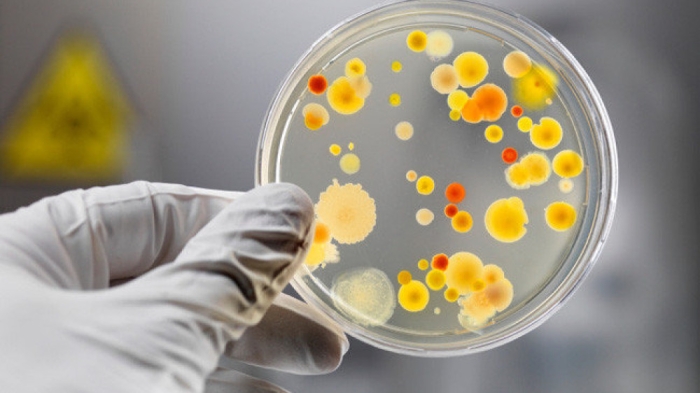
Заболеваемость выросла вдвое: санврачи предупредили алматинцев

Заболеваемость выросла вдвое: санврачи предупредили алматинцев
Фото:depositphotos.com В департаменте санитарно-эпидемиологического контроля Алматы сообщили о двукратном увеличении заболеваемости сальмонеллезом в городе, передает корреспондент Tengrinews.kz.
В департаменте санитарно-эпидемиологического контроля Алматы сообщили о двукратном увеличении заболеваемости сальмонеллезом в городе, передает корреспондент Tengrinews.kz. «За первые шесть месяцев 2024 года показатель заболеваемости сальмонеллезом в Алматы составил 1,40 на 100 тысяч населения, что в два раза выше по сравнению с показателем 0,67 за аналогичный период 2023 года. Дети до 14 лет составляют 25 процентов от общего числа заболевших», — сообщила заместитель руководителя департамента санитарно-эпидемиологического контроля города Асель Калыкова. По данным ведомства, большинство случаев заболевания связано с употреблением некачественных продуктов домашнего приготовления, которые не соответствовали требованиям технологии приготовления и условий хранения (мясо птицы, мясная и молочная продукция), а также с нарушением личной гигиены. В некоторых случаях заболевание было связано с употреблением пищи в общественных заведениях. В связи с этим эпидемиологи обратились к населению с просьбой соблюдать следующие меры профилактики: Врачи напомнили, что сальмонеллез является острым инфекционным заболеванием кишечника с фекально-оральным механизмом передачи, которое встречается круглый год, но чаще — летом из-за повышения температуры воздуха и нарушений условий хранения продуктов. Болезнь начинается остро, с повышением температуры тела, слабостью, головной болью, ознобом, тошнотой, иногда рвотой, болями в животе и нарушением стула, часто проявляющимися в виде гастроэнтерита или гастроэнтероколита. «При появлении признаков и симптомов сальмонеллеза необходимо незамедлительно обратиться за медицинской помощью и не заниматься самолечением», — отметили в ведомстве. Читайте также: Сальмонеллез и гепатит А: самый опасный салат назвали казахстанские санврачи.
Источник: tengrinews.kz